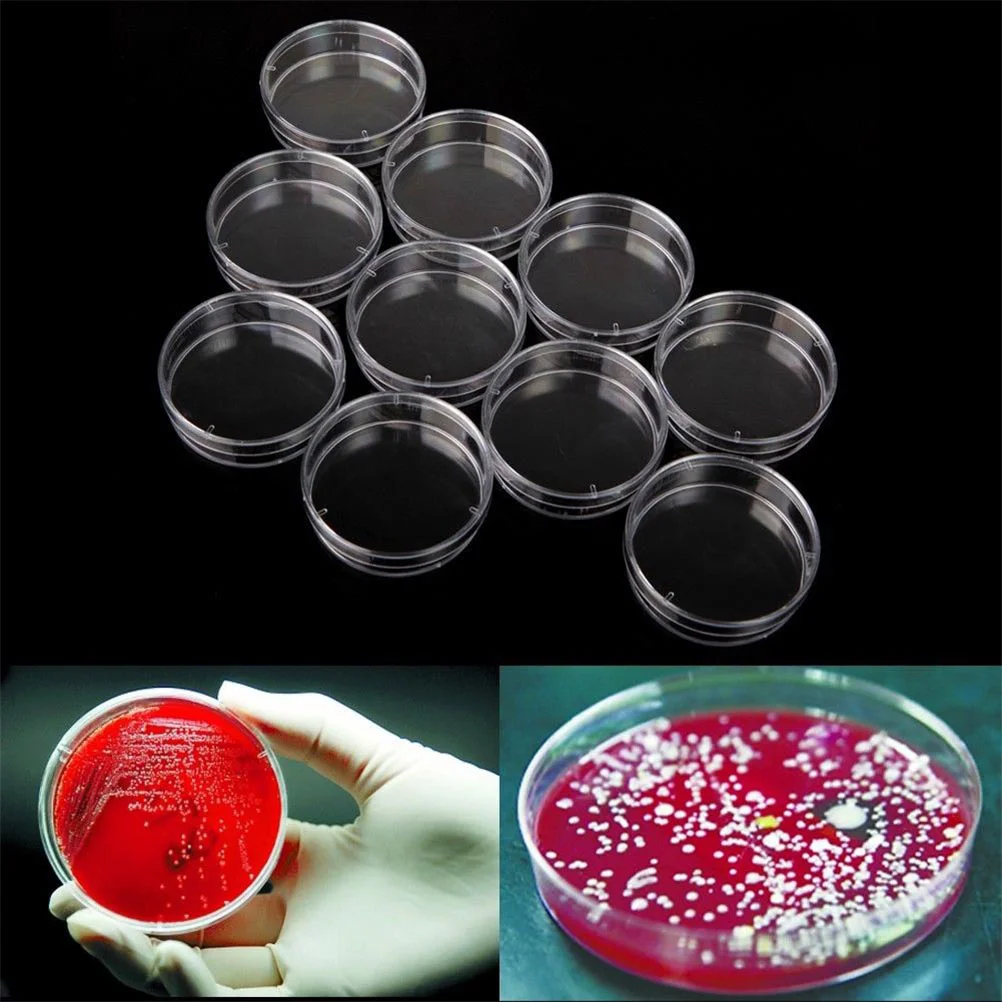
thumb

Чашка Петри с крышкой лабораторная чаша для культивирования тканей чаша Петри Обучающие чаши Петри аксессуары высококачественные клетчатые ткани
Price history chart & currency exchange rate
Customers also viewed

$9.47
Детская юбка-пачка для девочек, балетные пачки, эластичные 3-слойные тюлевые пачки с блестками
aliexpress.ru
$4.17
Детская фотография, 30 шт., тонкая марля, фотография, портативная и удобная, одноразовая фотография для ребенка
aliexpress.ru
$9.26
Роликовая боковая щетка, сменный комплект фильтра для Osoji 950, аксессуары для робота-пылесоса для подметания
aliexpress.ru
$11.65
2 шт., кнопка бесключевого доступа и ручки входной двери, резиновая крышка датчика для Mercedes Benz W164 R GL ML Class R300 ML320 (слева)
aliexpress.ru
$30.53
Thick Bottom Lace up Muffin Women's Leather round Head Pumps 2023 New Autumn Small White High-Heeled Shoes
aliexpress.com
$54.43
Luxury Custom Logo Car Leather Floor Mat 100% ForAcura All Models MDX ZDX RDX RL TL ILX CDX TLX-L Auto Accessories Carpet Cover
aliexpress.com
$4.51
M4x0.7 Fork Air Pressure Bleeder Relief Valves Set For KTM 50 150 200 250 350 400 450 500 525 530 EXC SX SXF XC XCW MXC
aliexpress.com
$3.89
New 8025 dual ball high rotation 12V 5V 24V chassis power supply motherboard PWM temperature control 8CM cooling fan80*80*25MM
aliexpress.com
$23.17
For MAXUS D90 PRO MG Gloster 2022 2023 Car Interior Gearpanel Dashboard Gps Navigation Screen Transparent TPU Protective Film
aliexpress.com
$11.45
10pcs Artificial Betta Leaf Fish Tank Plant Fish Oviposition Play Rest Bed Ornamental Plastic Plant Pet Fish Aqarium Decoration
aliexpress.com
$9.97
Cow Funny Men/women New Fashion Cool 3D Printed T-shirts Casual Style Tshirt Streetwear Tops Dropshipping
aliexpress.com
$11.81
Браслет Pixiu из Красного песка с высоким содержанием фиолетового золота, оригинальный каменный браслет, Женские Ювелирные изделия для рук, натуральные украшения
aliexpress.ru
$3.54
2023 мешок для стирки Sanming, сетчатый мешок для стирки, высококачественный мешок для стирки нижнего белья с вышивкой, мешок для стирки бюстгальтеров, специальная Сетчатая Сумка для машинной стирки
aliexpress.ru
$9.17
Умный водонепроницаемый датчик утечки воды, Wi-Fi погружной датчик 80 дБ с сигнализацией в режиме реального времени, Ip67
aliexpress.ru
$49.60
Suitable for Haval H9 luggage back door protection pad H9 luggage back door leather protection scratch pad
aliexpress.com
$13.57
Essential Oil Pure for Aromatherapy Diffuser humidifier Patchouli Cinnamon Hyacinth Sage Lemongrass Sea breeze Lavender Orange
aliexpress.ru
$328.99
Обеденный стол раскладной Skandi Wood SW079_R Нью-Йорк ⌀ 90 см (+35) х 90 х 76 см Массив Ясень Серый
rozetka.com.ua
$7.90
highlight tricolor dressing plate matte nose shadow face glitter powder shadow highlight powder powder powder blush powder
fordeal.com
$3.20
Scratch-resistant Gradient Glitter Powder Quicksand TPU Phone Shell with Strap for Samsung Galaxy A72 5G - Purple/Blue, Galaxy A72 5G
tvc-mall.com
$100.20
online influencer cute korean style cosmetic bag large capacity storage bag portable and versatile large and small size toiletries bag for women
fordeal.com
$798.74
DangBei F1 1080P Full HD DLP проектор 3GB RAM 32GB ROM Android 6.1 Домашний кинотеатр Поддержка Dual Band WiFi ЕС Plug, DangBei F1,DangBei,F1,1080P DLP Projector,DangBei F1 1080P DLP Projector
gearbest.com
$4.97
JoJo Bizarre Adventure Phone Case For iPhone 16,15,14,13,12,11,Pro,Max,Plus,X,XS,XR,SE,8,7,Mini,Soft Silicone Black Case
aliexpress.com
$26.39
In Stock Handmade Leather Goods Sheep Cross Dressing Hello Kitty Handbag Pendant Cute Car Keychain Girl'S Birthday Cute Gift
aliexpress.com
$32.80
Women Y2k T-shirt Harajuku Graphic Print Short Sleeve Turtleneck Tee Top Fashion Vintage Plaid T-shirts Summer 2000s Emo Clothes
aliexpress.com